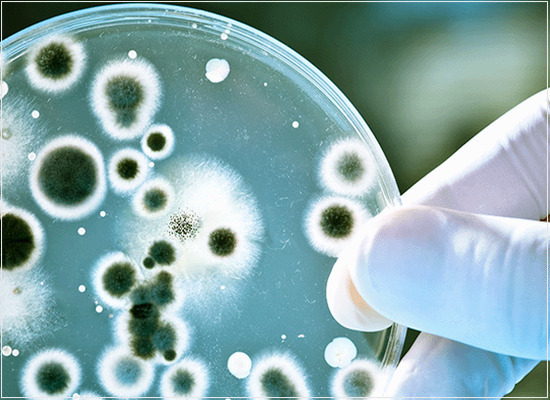
A determinação de endotoxinas bacterianas em produtos para saúde

Empresa com sistema de gestão da qualidade certificado
© Copyright 1994-2026 Target Engenharia e Consultoria Ltda.
Av. das Nações Unidas, 18801 - Cj. 1501 - São Paulo - SP | CEP 04795-000 - Brasil
Tel.: (11) 5641-4655 Ramal 881 - WhatsApp.: (11) 5525-5672 - CNPJ: 00.000.028/0001-29. Todos os direitos reservados.